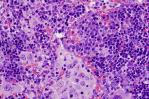

Un nuevo tratamiento aumenta la supervivencia en pacientes con cáncer de pulmón
El l fármaco osimertinib (Tagrisso®) después de la cirugía beneficiaba a los enfermos con cáncer de pulmón de células no pequeñas (NSCLC) en fase IB, II o IIIA.

El tratamiento contra el cáncer de pulmón ha descubierto una nueva vía que aumenta la supervivencia en aquellos enfermos en los que se ha detectado una mutación del gen EGFR.
El estudio, impulsado por la farmacéutica AstraZeneca, fue presentado este domingo en Chicago, en el marco del congreso anual de la Sociedad Americana de Oncología Clínica (ASCO, por sus siglas en inglés).
El tratamiento con el fármaco osimertinib (Tagrisso®) después de la cirugía, según las conclusiones de ese ensayo bautizado ADAURA, beneficiaba a los enfermos con cáncer de pulmón de células no pequeñas (NSCLC) en fase IB, II o IIIA.
Veintiséis países de Europa, Norte y Suramérica y Asia-Pacífico participaron en el mismo.
De los 682 pacientes, con edades comprendidas entre los 30 y los 86 años, aproximadamente dos tercios eran mujeres. La edad media del grupo que recibió osimertinib era de 64 años, y de 62 en quienes recibieron placebo.
Cerca de dos tercios no eran fumadores y también alrededor de dos tercios eran asiáticos.
El estudio precisa que cinco años después de la operación el riesgo de muerte en los pacientes con cáncer NSCLC en fases IB-IIIA y a los que se les trató con osimertinib fue un 51 % inferior que en aquellos a los que les tocó el placebo.
La tasa de supervivencia fue además del 88 % para el primer grupo y del 78 % entre quienes se quedaron con el placebo.
El oncólogo Roy Herbst, autor del estudio y subdirector del Yale Cancer Center, recordó en su presentación en la sesión plenaria que el cáncer de pulmón es la principal causa de muerte global por cáncer.
Es responsable de 1,8 millones de fallecimientos cada año. El NSCLC representa alrededor del 80 % de todos los diagnósticos y cerca de un 30 % de los pacientes puede ser operado.
La mutación EGFR se da en entre el 10 y el 50 % de pacientes con NSCLC, según los datos de Herbst.
A pesar del uso de la quimioterapia después de la extirpación quirúrgica, las tasas de recaída en las fases IB-IIIA son altas y aumentan en estadios posteriores.
Hasta ahora la tasa de supervivencia 5 años después de la operación en pacientes con cáncer NSCLC que puede ser operable es del 65-75 % en fase IB, del 50-70 % en la II y del 30-40 % en la IIIA.
Esto hace que osimertinib gane fuerza como tratamiento estándar para esas personas y, según el vicepresidente ejecutivo de la división de Oncología de AstraZeneca, Dave Fredrickson, es la primera vez que la medicina de precisión obtiene un éxito de ese tipo y logra mejorar la tasa de supervivencia.
El 85 % de los casos de cáncer de pulmón se diagnostica tarde
La terapia combinada sube un 20 % la supervivencia en tumor de pulmón intermedio
"La medicina de precisión abre la oportunidad de tratar en un estadio más temprano. En el cáncer de pulmón esto es muy importante", explica el directivo a EFE, subrayando la importancia de que ese tipo de cáncer pueda ser diagnosticado en una fase inicial.

EFE